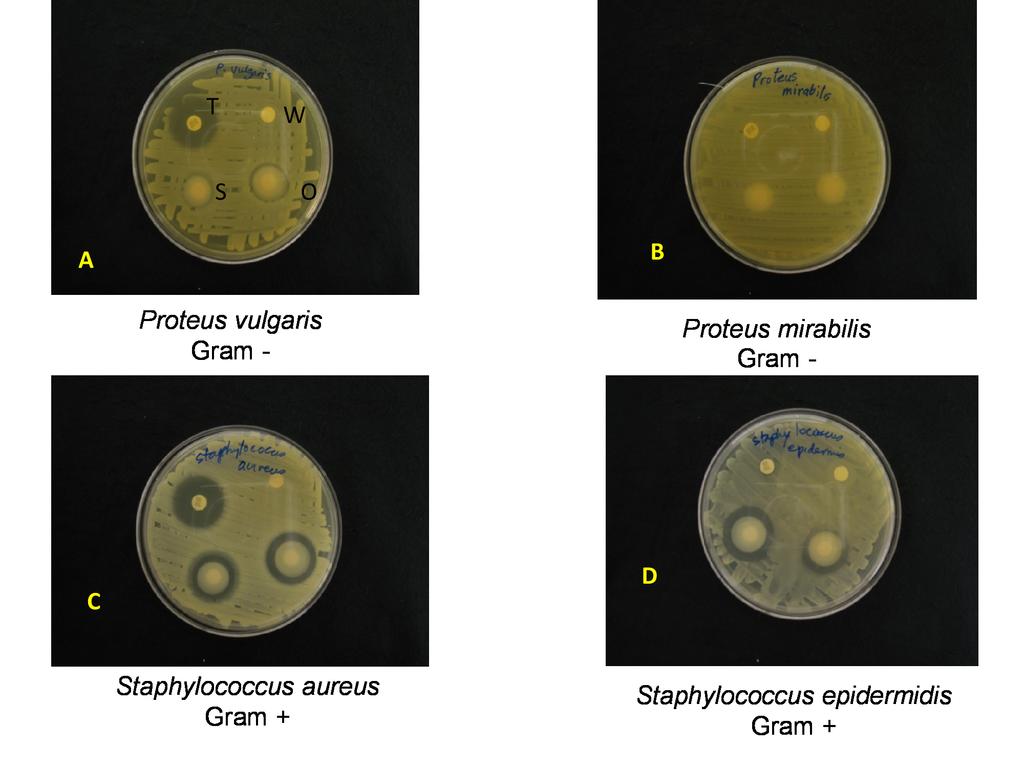
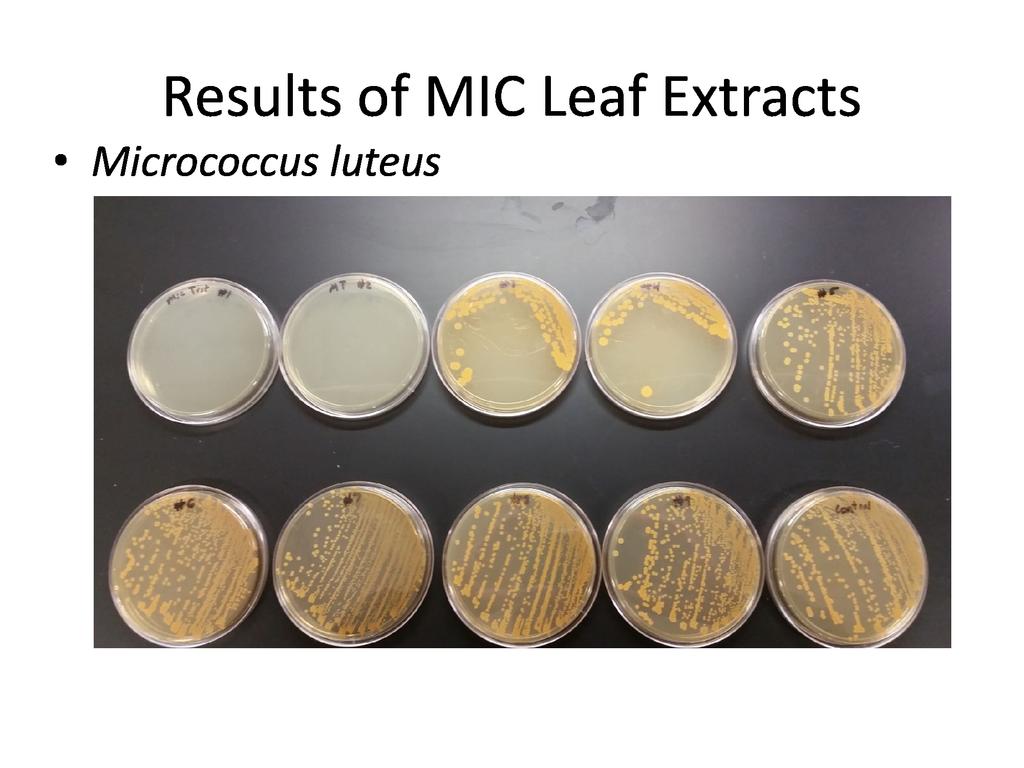
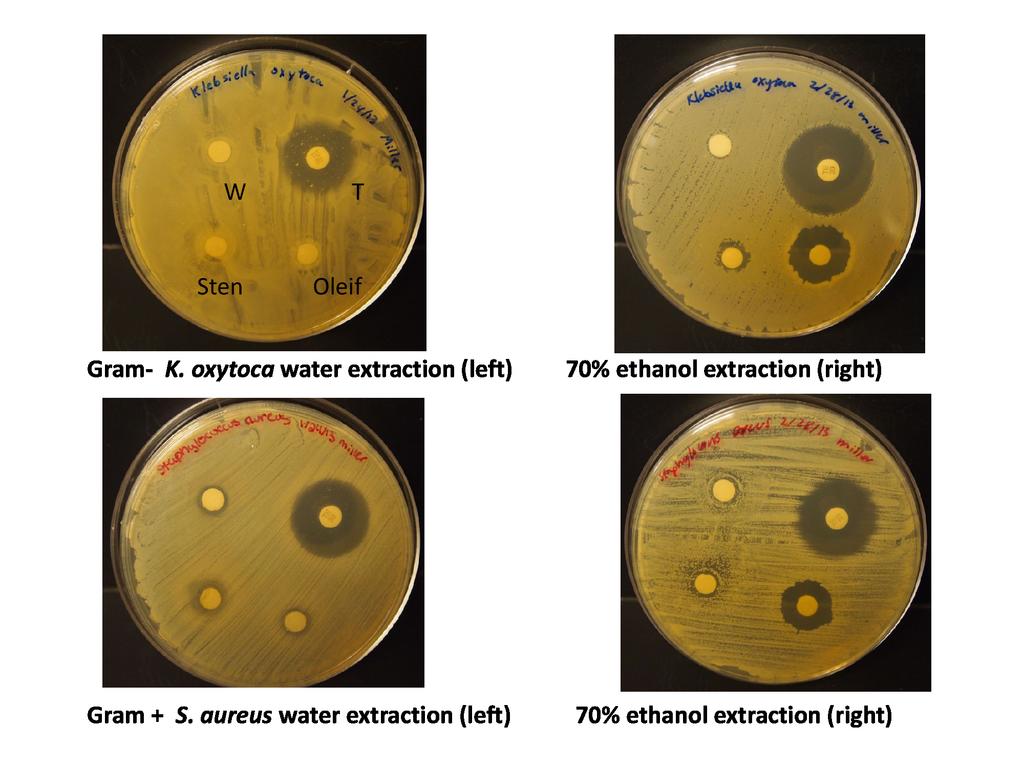
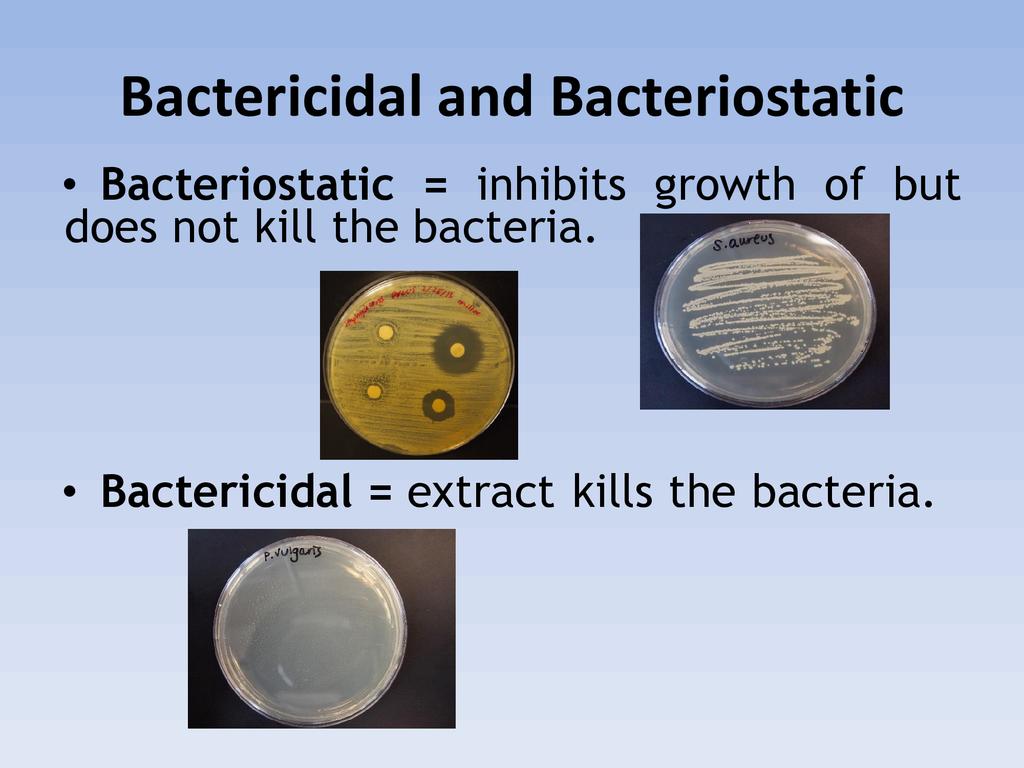

Presented By: Grace Ju Miller
Event: ECHO International Agriculture Conference 2019 (2019-11-19)
Session : Grace has been conducting Moringa research for 20 years with undergraduate students. This presentation will be a research update on moringa as an antibacterial plant and water purification option. Tissue culture and regeneration of moringa, as well as future use in biotechnology, nutrition and pharmacology will be discussed.
Presenter : Dr. Grace Miller is the Dean of the School of Natural and Applied Sciences at Taylor University. She has worked in Sustainable Agriculture for 20 years. Grace has worked as the ECHO Seed Bank Director and was on the ECHO Board. She has taught Sustainable Tropical Agriculture courses in Haiti, Nicaragua, Honduras, and Guatemala. Grace also worked in Taiwan for 2.5 years and worked in Morocco for 2 years.